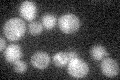
YLR068W
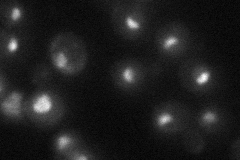
YLR068W
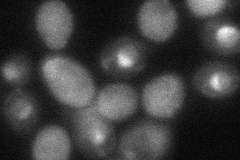
YLR068W

View description
Essential protein required for maturation of 18S rRNA; required for survival upon exposure to K1 killer toxin
Localization:
Intensity:
Fold change:
Significance:
-
C’ GFP library in SD
below threshold17.07 -
N' NOP1pr-GFP in SD

nucleolus175.355 -
N' TEF2pr-mCherry in SD

nucleus,nucleolus116.375 -
N' NATIVEpr-GFP in SD
nucleolus35.2227 -
N' TEF2pr-VC and Cyto-VN in SD
nucleus,nucleolus51.092 -
C’ GFP library in SD+DTT

cytosol18.231.06No -
C’ GFP library in SD+H2O2

cytosol12.690.74No -
C’ GFP library in Starvation Media

cytosol15.880.92No -
C’ GFP library on the background of Pup2-DaMP

below threshold -
C’ GFP library on the background of CCT mutant

below threshold16.07560.941337No
